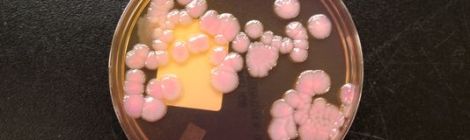
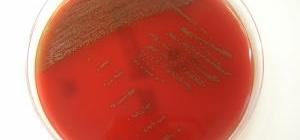

Noticias: Investigadores de la Universidad de Okayama y del Instituto Forsyth desarrollan nueva estrategia para el tratamiento de conductos radiculares
Resolvin D2 Induces Resolution of Periapical Inflammation and Promotes Healing of Periapical Lesions in Rat Periapical Periodontitis. Abstract: Periapical periodontitis results from pulpal infection leading to pulpal necrosis and resorption […]

Debe estar conectado para enviar un comentario.